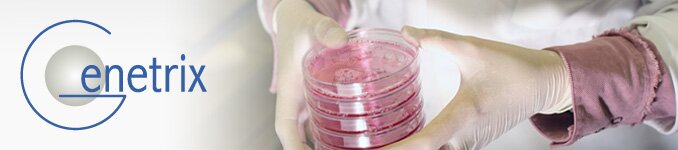
Genetrix Genetrix

Genetrix
Oportunidades en el sector biotecnológico
Genetrix desarrolla y comercializa productos y servicios innovadores que ofrecen soluciones biotecnológicas a demandas del mercado.
La estructura de Genetrix, formada por compañías de tecnologías y biomedicina, se ha desarrollado para maximizar el valor del grupo
El apoyo de científicos de prestigio internacional ha permitido desarrollar a la compañía un avanzado pipeline de productos


